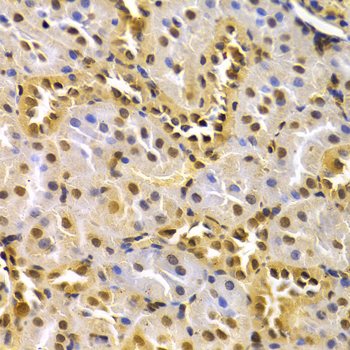
A0366: image 4

For quotations, please use our online quotation form, and you may also contact us by
sales@neoscientific.com
+1-888.733.6849
+1-617.299.7367 (Int’l)
+1-888.733.6849
+1-617.299.7367 (Int’l)
| Reactivity | Human Mouse Rat | 
| Tested applications | WB IHC IF | 
| Recommended Dilution | WB 1:500 - 1:2000 IHC 1:50 - 1:200 IF 1:20 - 1:100 | 
| Calculated MW | 34kDa | 
| Observed MW | Refer to Figures | 
| Immunogen | Recombinant protein of human CDK4 | 
| Storage Buffer | Store at -20℃. Avoid freeze / thaw cycles. Buffer: PBS with 0.02% sodium azide, 50% glycerol, pH7.3. | 
| Synonym | CDK4;CMM3;MGC14458;PSK-J3 ; | 

Western blot analysis of extracts of various cell lines, using CDK4 antibody.

Immunohistochemistry of paraffin-embedded rat lung using CDK4 antibody at dilution of 1:100 (x400 lens).

Immunohistochemistry of paraffin-embedded rat liver using CDK4 antibody at dilution of 1:100 (x400 lens).
Immunohistochemistry of paraffin-embedded rat kidney using CDK4 antibody at dilution of 1:100 (x400 lens).

Immunohistochemistry of paraffin-embedded human liver injury using CDK4 antibody at dilution of 1:100 (x400 lens).
Cyclin-dependent kinase activity is regulated by T-loop phosphorylation (Thr172 in the case of CDK4), by the abundance of their cyclin partners, and by association with CDK inhibitors of the Cip/Kip or INK family of proteins (1). The inactive ternary complex of CDK4/cyclin D and p27 Kip1/Cip1 requires extracellular mitogenic stimuli for the release and degradation of p27, which affects progression through the restriction point and pRb-dependent entry into S-phase (2). The active complex of CDK4/cyclin D targets the retinoblastoma protein for phosphorylation, allowing the release of E2F transcription factors that activate G1/S-phase gene expression (3). In HeLa cells, upon UV irradiation, upregulation of p16 INK4A association with CDK4/cyclin D3 leads to a G2 delay, implicating CDK4/cyclin D3 activity in progression through the G2-phase of the cell cycle (4).
N/A